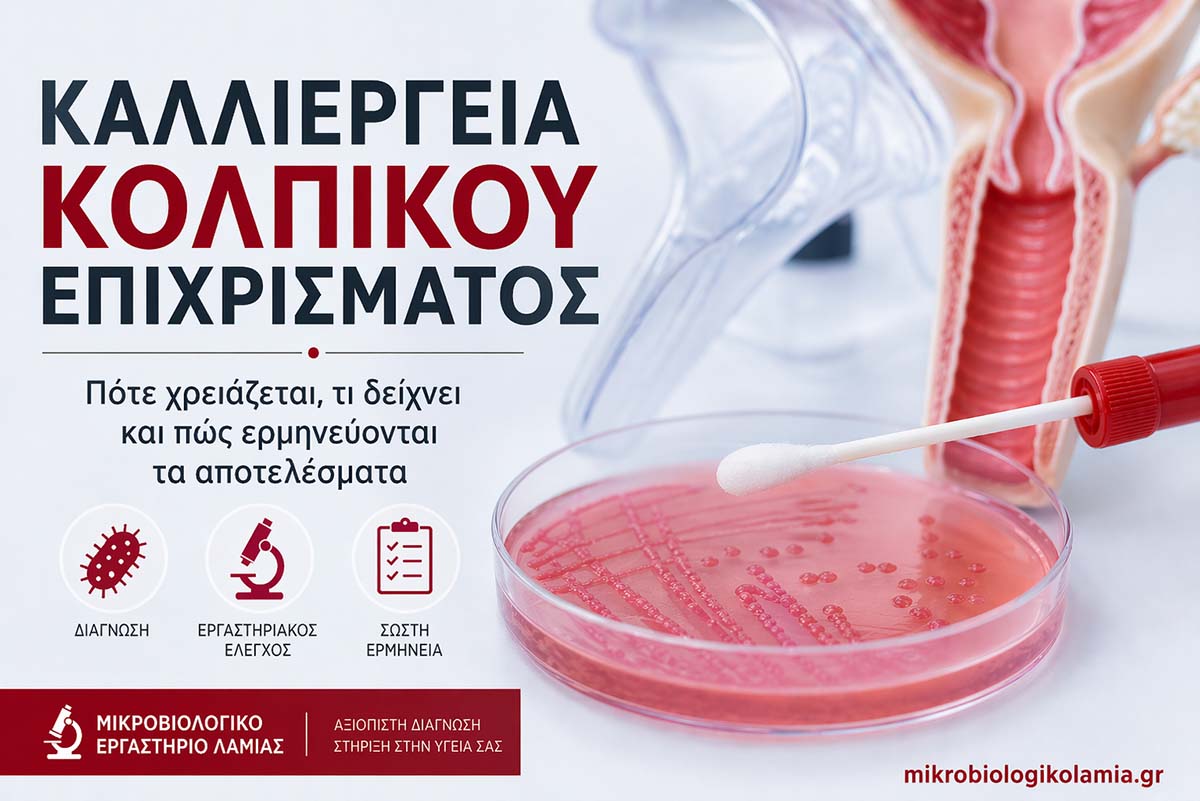
kalliergeia-kolpikou-epichrismatos-exetasi-kolpitidas-mikrobiologikolamia-1200x800-1.jpg

Ουρολοίμωξη: συμπτώματα, διάγνωση, θεραπεία, πρόληψη & τι δείχνουν οι εξετάσεις ούρων
Σύντομη περίληψη:
Η ουρολοίμωξη είναι μία από τις πιο συχνές λοιμώξεις, ιδιαίτερα στις γυναίκες, και συνήθως αφορά την ουροδόχο κύστη (κυστίτιδα). Τα πιο συχνά συμπτώματα είναι τσούξιμο στην ούρηση, συχνουρία, επιτακτική ανάγκη για ούρηση και ενόχληση χαμηλά στην κοιλιά.
Η διάγνωση βασίζεται στο ιστορικό, στη γενική ούρων και, όταν χρειάζεται, στην καλλιέργεια ούρων με αντιβιόγραμμα. Δεν χρειάζεται κάθε ενόχλημα αυτομάτως αντιβιοτικό και δεν χρειάζεται κάθε θετική καλλιέργεια θεραπεία.
Ιδιαίτερη προσοχή χρειάζεται όταν υπάρχει πυρετός, πόνος στη μέση, εγκυμοσύνη, ουρολοίμωξη σε άνδρα, συχνές υποτροπές ή συνοδά προβλήματα όπως λίθος, καθετήρας, σακχαρώδης διαβήτης ή νεφρική νόσος.
1Τι είναι η ουρολοίμωξη
Η ουρολοίμωξη είναι λοίμωξη που αφορά κάποιο τμήμα του ουροποιητικού συστήματος, δηλαδή την ουρήθρα, την ουροδόχο κύστη, τους ουρητήρες ή τους νεφρούς. Στην καθημερινή πράξη, όταν ένας ασθενής λέει «έχω ουρολοίμωξη», συχνότερα εννοεί κυστίτιδα, δηλαδή λοίμωξη της κύστης. Όμως ο όρος περιλαμβάνει και πιο σοβαρές καταστάσεις, όπως η πυελονεφρίτιδα, όπου η λοίμωξη φτάνει στον νεφρό και μπορεί να συνοδεύεται από πυρετό, ρίγος, ναυτία και έντονο πόνο στη μέση.
Η ουρολοίμωξη είναι πολύ συχνή, ιδιαίτερα στις γυναίκες, επειδή η γυναικεία ουρήθρα είναι μικρότερη και τα μικρόβια από την περιγεννητική περιοχή μπορούν ευκολότερα να φτάσουν στην κύστη. Αυτό δεν σημαίνει ότι κάθε ενόχληση στην ούρηση είναι ουρολοίμωξη. Το τσούξιμο μπορεί επίσης να οφείλεται σε κολπίτιδα, σεξουαλικώς μεταδιδόμενη λοίμωξη, ερεθισμό από προϊόντα υγιεινής ή λιγότερο συχνά σε λίθο, φλεγμονώδη κατάσταση ή άλλη πάθηση της ουροδόχου κύστης.
Από ιατρικής πλευράς, έχει σημασία να ξεχωρίζουμε την απλή λοίμωξη του κατώτερου ουροποιητικού από την λοίμωξη που σχετίζεται με πυρετό, απόφραξη, λίθο, κύηση, καθετήρα, νεφρική δυσλειτουργία ή άλλα προβλήματα. Αυτές οι λεπτομέρειες αλλάζουν το πώς ερμηνεύουμε τις εξετάσεις και το πόσο άμεσα πρέπει να δοθεί θεραπεία.
2Ποια συμπτώματα προκαλεί
Τα κλασικά συμπτώματα της ουρολοίμωξης του κατώτερου ουροποιητικού είναι το τσούξιμο ή κάψιμο στην ούρηση, η συχνουρία, η επιτακτική ανάγκη για ούρηση και η αίσθηση ότι η κύστη δεν αδειάζει καλά. Πολλοί ασθενείς περιγράφουν ότι πηγαίνουν συνεχώς στην τουαλέτα αλλά βγάζουν μικρές ποσότητες ούρων. Συχνά υπάρχει ενόχληση ή βάρος χαμηλά στην κοιλιά, ενώ τα ούρα μπορεί να είναι θολά, με έντονη οσμή ή να συνοδεύονται από μικρή αιματουρία.
Όταν όμως η λοίμωξη «ανεβαίνει» προς τον νεφρό, η εικόνα αλλάζει. Μπορεί να εμφανιστεί πυρετός, ρίγος, πόνος στη μέση ή στο πλάι, ναυτία, έμετος και γενική καταβολή. Αυτή η εικόνα δεν είναι απλή κυστίτιδα και χρειάζεται πιο άμεση αξιολόγηση, γιατί αυξάνεται ο κίνδυνος αφυδάτωσης, βακτηριαιμίας ή ακόμη και σήψης σε ευπαθή άτομα.
Στους ηλικιωμένους η διάγνωση δεν είναι πάντα τόσο «καθαρή». Μπορεί να υπάρχουν γενικά συμπτώματα, αδυναμία ή αλλαγή συμπεριφοράς, χωρίς όμως κάθε θετική γενική ούρων να σημαίνει ότι όλα οφείλονται σε ουρολοίμωξη. Ειδικά σε ηλικιωμένους, σε άτομα με καθετήρα ή σε χρόνιες παθήσεις, χρειάζεται προσοχή για να μη βαφτίζεται ως λοίμωξη κάθε τυχαίο εύρημα στα ούρα.
3Πότε χρειάζεται άμεση ιατρική εκτίμηση
Δεν έχουν όλες οι ουρολοιμώξεις την ίδια βαρύτητα. Μία νέα γυναίκα με τσούξιμο και συχνουρία, χωρίς πυρετό και χωρίς συνοδά προβλήματα, διαφέρει σημαντικά από μια έγκυο, έναν άνδρα με δυσουρία ή έναν ηλικιωμένο με πυρετό και καθετήρα. Γι’ αυτό υπάρχουν περιπτώσεις στις οποίες δεν αρκεί απλώς «να κάνω μια γενική ούρων όταν βρω χρόνο».
Άμεση επικοινωνία με γιατρό ή επείγουσα αξιολόγηση χρειάζεται όταν υπάρχει πυρετός ≥38°C, ρίγος, πόνος στη μέση ή στο πλάι, έμετοι, αδυναμία λήψης υγρών, έντονη αιματουρία, σημαντικός πόνος, υπόταση ή αίσθημα λιποθυμίας. Επίσης χρειάζεται γρηγορότερη αξιολόγηση όταν η ουρολοίμωξη αφορά έγκυο, παιδί, άνδρα, άτομο με μόνο έναν λειτουργικό νεφρό, με πρόσφατη ουρολογική επέμβαση, με καθετήρα, με γνωστό λίθο ή με σοβαρή ανοσοκαταστολή.
Αν ξεκινήσει θεραπεία και τα συμπτώματα δεν βελτιώνονται μέσα σε 48–72 ώρες, χρειάζεται επανεκτίμηση. Το ίδιο ισχύει όταν τα συμπτώματα υποχωρούν αρχικά και επανέρχονται πολύ γρήγορα, γιατί τότε μπορεί να υπάρχει ανθεκτικό μικρόβιο, λάθος διάγνωση ή κάποιος παράγοντας που συντηρεί τη λοίμωξη.
4Κυστίτιδα, πυελονεφρίτιδα ή ασυμπτωματική βακτηριουρία;
Ένα από τα πιο συχνά λάθη είναι να μπαίνουν όλες οι περιπτώσεις κάτω από την ίδια ταμπέλα. Η κυστίτιδα είναι συνήθως λοίμωξη της κύστης, με συμπτώματα από την ούρηση αλλά χωρίς σημεία συστηματικής λοίμωξης. Η πυελονεφρίτιδα αφορά τον νεφρό και είναι πιο σοβαρή. Η ασυμπτωματική βακτηριουρία σημαίνει ότι βρέθηκαν βακτήρια στα ούρα, αλλά ο ασθενής δεν έχει συμπτώματα ουρολοίμωξης.
Η ασυμπτωματική βακτηριουρία έχει ιδιαίτερη σημασία, γιατί δεν θεραπεύεται πάντα. Σε πολλές ομάδες ασθενών η ανεύρεση βακτηρίων στα ούρα χωρίς συμπτώματα δεν σημαίνει ότι χρειάζεται αντιβίωση. Αντίθετα, η άσκοπη θεραπεία αυξάνει τις αντοχές, διαταράσσει το μικροβίωμα και μπορεί να οδηγήσει σε περιττές παρενέργειες. Εξαιρέσεις υπάρχουν, κυρίως στην εγκυμοσύνη και πριν από ορισμένες ουρολογικές επεμβάσεις.
| Κατάσταση | Τυπικά συμπτώματα | Τι δείχνουν οι εξετάσεις | Συνήθης αντιμετώπιση |
|---|---|---|---|
| Κυστίτιδα | Τσούξιμο, συχνουρία, επιτακτική ούρηση, υπερηβικός πόνος | Λευκοκύτταρα, νιτρώδη, μικροβιουρία ± αιματουρία | Στοχευμένη θεραπεία, συχνά βραχεία αγωγή |
| Πυελονεφρίτιδα | Πυρετός, ρίγος, πόνος στη μέση/πλάγια, ναυτία, καταβολή | Γενική ούρων + υποχρεωτικά καλλιέργεια, συχνά και αιματολογικός έλεγχος | Πιο επιθετική αντιμετώπιση, ενίοτε νοσηλεία |
| Ασυμπτωματική βακτηριουρία | Δεν υπάρχουν συμπτώματα ουρολοίμωξης | Θετική καλλιέργεια χωρίς συμβατή κλινική εικόνα | Συνήθως όχι θεραπεία, εκτός ειδικών εξαιρέσεων |
Αυτός ο διαχωρισμός εξηγεί γιατί δεν αρκεί να κοιτάμε μόνο ένα χαρτί εξετάσεων. Η κλινική εικόνα παραμένει κεντρική. Ένα «θετικό ουροποιητικό» χωρίς συμπτώματα δεν σημαίνει πάντα λοίμωξη που πρέπει να θεραπευτεί.
5Πώς προκαλείται και ποια μικρόβια ευθύνονται
Στις περισσότερες περιπτώσεις, η ουρολοίμωξη προκαλείται από βακτήρια της εντερικής χλωρίδας που φτάνουν στην ουρήθρα και από εκεί στην κύστη. Το πιο συχνό μικρόβιο είναι το Escherichia coli (E. coli). Αυτό δεν είναι περίεργο: πρόκειται για μικρόβιο που ζει φυσιολογικά στο έντερο, αλλά όταν περάσει στο ουροποιητικό μπορεί να προκαλέσει λοίμωξη.
Εκτός από το E. coli, μπορεί να ευθύνονται και άλλα βακτήρια, όπως Klebsiella, Proteus, Enterococcus ή άλλα νοσοκομειακά και ανθεκτικά μικρόβια, κυρίως όταν υπάρχουν καθετήρες, πρόσφατες νοσηλείες, προηγούμενα πολλαπλά αντιβιοτικά ή υποκείμενες ουρολογικές ανωμαλίες. Σε ορισμένες περιπτώσεις, το είδος του μικροβίου δίνει και διαγνωστικές πληροφορίες. Για παράδειγμα, η παρουσία Proteus μπορεί να σχετίζεται με λίθους.
Η διαδικασία ξεκινά συχνότερα ως ανιούσα λοίμωξη: τα μικρόβια μπαίνουν από την ουρήθρα και κινούνται προς τα πάνω. Γι’ αυτό παράγοντες που ευνοούν τη μεταφορά μικροβίων ή την παραμονή ούρων στην κύστη αυξάνουν τον κίνδυνο. Όταν τα ούρα λιμνάζουν, όταν υπάρχει απόφραξη, όταν η κύστη δεν αδειάζει καλά ή όταν υπάρχουν ξένα σώματα όπως καθετήρες, τα βακτήρια βρίσκουν πιο εύκολα χρόνο και χώρο για να πολλαπλασιαστούν.
6Παράγοντες κινδύνου
Οι πιο γνωστοί παράγοντες κινδύνου στις γυναίκες είναι η σεξουαλική δραστηριότητα, η χρήση σπερματοκτόνων, η ύπαρξη νέου σεξουαλικού συντρόφου, το ατομικό ιστορικό προηγούμενων ουρολοιμώξεων και, σε ορισμένες περιπτώσεις, η οικογενειακή προδιάθεση. Στις μετεμμηνοπαυσιακές γυναίκες, η μείωση των οιστρογόνων αλλάζει το κολπικό μικροπεριβάλλον και μπορεί να αυξήσει την προδιάθεση σε υποτροπές.
Σε άνδρες, ο κίνδυνος αυξάνει όταν υπάρχει διόγκωση προστάτη, ατελής κένωση της κύστης, ανατομική ανωμαλία ή ουρολογικό πρόβλημα που δυσκολεύει τη ροή των ούρων. Σε άτομα κάθε φύλου, σημαντικοί παράγοντες είναι ο σακχαρώδης διαβήτης, η νεφρική νόσος, οι λίθοι, η νευρογενής κύστη, η χρήση καθετήρα, οι πρόσφατες ουρολογικές πράξεις και η ανοσοκαταστολή.
Υπάρχουν επίσης λειτουργικοί παράγοντες που δεν φαίνονται σε μια απλή εξέταση: καθυστέρηση της ούρησης, μειωμένη πρόσληψη υγρών, δυσκοιλιότητα, κακή κένωση κύστης, αλλά και επαναλαμβανόμενη λήψη αντιβιοτικών που ευνοεί ανθεκτικά στελέχη. Για αυτό, σε ασθενείς με συχνές υποτροπές δεν αρκεί να επαναλαμβάνεται η αντιβίωση. Χρειάζεται να αναζητηθεί γιατί επανέρχεται το πρόβλημα.
7Πώς γίνεται η διάγνωση
Η διάγνωση ξεκινά από το ιστορικό. Σε γυναίκες χωρίς ειδικούς παράγοντες κινδύνου, με τυπικά συμπτώματα όπως δυσουρία, συχνουρία και επιτακτική ούρηση, χωρίς κολπικό έκκριμα ή ερεθισμό, η πιθανότητα κυστίτιδας είναι υψηλή. Αυτό σημαίνει ότι σε ορισμένες περιπτώσεις η διάγνωση μπορεί να τεθεί κυρίως κλινικά, χωρίς να χρειάζεται πάντα πλήρης εργαστηριακός έλεγχος πριν από κάθε απόφαση.
Ωστόσο, η κλινική διάγνωση δεν αρκεί σε όλους. Καλλιέργεια ούρων χρειάζεται συχνότερα όταν υπάρχει υποψία πυελονεφρίτιδας, εγκυμοσύνη, ουρολοίμωξη σε άνδρα, παιδί, άτυπα συμπτώματα, αποτυχία της αρχικής θεραπείας, πολύ γρήγορη υποτροπή ή υποψία ανθεκτικού μικροβίου. Στις περιπτώσεις αυτές, η καλλιέργεια δεν είναι τυπική πολυτέλεια· είναι εργαλείο για να βρεθεί το μικρόβιο και να επιλεγεί το σωστό αντιβιοτικό.
Η γενική ούρων παραμένει εξαιρετικά χρήσιμη, γιατί δείχνει στοιχεία όπως λευκοκύτταρα, νιτρώδη, ερυθρά, βακτηρίδια και πυοσφαίρια. Όμως πρέπει να διαβάζεται στο σωστό πλαίσιο. Μια γενική ούρων από κακοσυλλεγμένο δείγμα μπορεί να μπερδέψει. Και μια ήπια λευκοκυτταρουρία χωρίς συμβατή κλινική εικόνα δεν αρκεί από μόνη της για να μπει διάγνωση ουρολοίμωξης.
8Σωστή συλλογή δείγματος ούρων
Η σωστή συλλογή δείγματος είναι από τα πιο κρίσιμα βήματα. Πολλές «ύποπτες» ή αντιφατικές εξετάσεις οφείλονται σε κακή λήψη του δείγματος και όχι σε περίπλοκη λοίμωξη. Για γενική ούρων και καλλιέργεια, συνήθως προτιμάται δείγμα μέσης ούρησης. Αυτό σημαίνει ότι απορρίπτετε την πρώτη μικρή ποσότητα και συλλέγετε το ενδιάμεσο ρεύμα σε καθαρό, αποστειρωμένο δοχείο.
Πριν από τη συλλογή, χρειάζεται καθαρισμός της περιοχής χωρίς υπερβολές και χωρίς αντισηπτικά που μπορεί να αλλοιώσουν το αποτέλεσμα. Στις γυναίκες βοηθά η απομάκρυνση των χειλέων κατά τη διάρκεια της ούρησης, ενώ στους άνδρες η αποκάλυψη της βαλάνου εφόσον υπάρχει πόσθη. Αν η καλλιέργεια καθυστερήσει, το δείγμα πρέπει να παραδοθεί γρήγορα ή να φυλαχθεί όπως έχει συστηθεί από το εργαστήριο, γιατί ο χρόνος και η θερμοκρασία αλλάζουν τη μικροβιακή εικόνα.
Σε ειδικές ομάδες, όπως βρέφη, ασθενείς με καθετήρα ή άτομα που δεν μπορούν να συνεργαστούν, η λήψη γίνεται διαφορετικά και ιδανικά με σαφείς οδηγίες από τον παιδίατρο, τον ουρολόγο ή το εργαστήριο. Δεν πρέπει να γίνεται ερμηνεία δύσκολου δείγματος σαν να ήταν κλασικό, σωστά ληφθέν δείγμα μέσης ούρησης.
| Βήμα | Τι κάνετε | Γιατί έχει σημασία |
|---|---|---|
| 1 | Καθαρίζετε απαλά την περιοχή | Μειώνει τη μόλυνση του δείγματος από εξωτερικά μικρόβια |
| 2 | Απορρίπτετε την πρώτη ροή | Απομακρύνονται μικρόβια/κύτταρα της ουρήθρας |
| 3 | Συλλέγετε τη μέση ούρηση σε αποστειρωμένο δοχείο | Το δείγμα αντιπροσωπεύει καλύτερα την κύστη |
| 4 | Το παραδίδετε σύντομα | Αποφεύγεται αλλοίωση του αποτελέσματος |
9Τι δείχνουν η γενική ούρων, η καλλιέργεια και το αντιβιόγραμμα
Η γενική ούρων είναι η πιο γρήγορη αρχική εξέταση. Τα λευκοκύτταρα και η λευκοκυτταρική εστεράση δείχνουν φλεγμονώδη αντίδραση. Τα νιτρώδη μπορεί να είναι θετικά όταν ορισμένα βακτήρια μετατρέπουν τα νιτρικά άλατα. Η αιματουρία είναι συχνή σε κυστίτιδα, αλλά δεν είναι ειδική· μπορεί να υπάρχει και σε λίθο, νεοπλασία ή άλλο ερεθισμό. Γι’ αυτό δεν διαβάζουμε ποτέ μία μόνο παράμετρο απομονωμένα.
Η καλλιέργεια ούρων απαντά στο ερώτημα «ποιο μικρόβιο αναπτύχθηκε;» και σε ποια ποσότητα. Έτσι επιβεβαιώνεται συχνά αν πρόκειται για πραγματική λοίμωξη ή για επιμόλυνση. Το αντιβιόγραμμα δείχνει σε ποια αντιβιοτικά το συγκεκριμένο μικρόβιο είναι ευαίσθητο ή ανθεκτικό. Αυτή η πληροφορία είναι ιδιαίτερα σημαντική όταν η λοίμωξη δεν είναι απλή, όταν υπάρχουν υποτροπές ή όταν η πρώτη εμπειρική θεραπεία δεν πέτυχε.
Στο εργαστήριο, πολλές φορές χρειάζεται να εξηγηθεί ότι μια θετική καλλιέργεια χωρίς συμπτώματα δεν ισοδυναμεί πάντοτε με νόσο που χρειάζεται θεραπεία. Επίσης, μια γενική ούρων με ήπια διαταραχή δεν αρκεί από μόνη της για να τεθεί διάγνωση. Η ερμηνεία πρέπει να συνδέεται με το ιστορικό, την ηλικία, το φύλο, την εγκυμοσύνη, τον καθετήρα, τις υποτροπές και τη συνολική κλινική εικόνα.
| Εξέταση/εύρημα | Τι σημαίνει συχνότερα | Τι δεν σημαίνει απαραίτητα |
|---|---|---|
| Λευκοκύτταρα / πυοσφαίρια | Φλεγμονή ή ερεθισμός στο ουροποιητικό | Δεν αποδεικνύουν μόνα τους βακτηριακή λοίμωξη |
| Θετικά νιτρώδη | Συνηγορούν υπέρ ορισμένων βακτηρίων, συχνά Gram-αρνητικών | Αρνητικά νιτρώδη δεν αποκλείουν ουρολοίμωξη |
| Αιματουρία | Συμβατή με κυστίτιδα ή ερεθισμό | Μπορεί να οφείλεται και σε λίθο, τραύμα ή άλλη πάθηση |
| Θετική καλλιέργεια | Ανάπτυξη μικροβίου στα ούρα | Δεν σημαίνει πάντα ότι χρειάζεται θεραπεία αν δεν υπάρχουν συμπτώματα |
| Αντιβιόγραμμα | Καθοδηγεί την επιλογή αντιβιοτικού | Δεν αντικαθιστά την κλινική εκτίμηση και το ιστορικό |
10Θεραπεία της απλής ουρολοίμωξης
Η θεραπεία της απλής κυστίτιδας εξαρτάται από το ιστορικό, το φύλο, την εγκυμοσύνη, τις αλλεργίες, τα συνοδά νοσήματα και τις τοπικές αντοχές των μικροβίων. Στην καθημερινή πράξη, ο γιατρός μπορεί να επιλέξει ένα βραχύ σχήμα αντιβίωσης όταν πρόκειται για τυπική, απλή κυστίτιδα. Συχνές επιλογές σε πολλές κατευθυντήριες οδηγίες είναι φάρμακα όπως η φωσφομυκίνη ή η νιτροφουραντοΐνη, αλλά η τελική απόφαση είναι πάντα εξατομικευμένη και όχι «ένα φάρμακο για όλους».
Σε κάποιες ασθενείς, μπορεί να συζητηθεί και η ανακουφιστική υποστήριξη, όπως επαρκή υγρά και αντιμετώπιση του πόνου, όμως αυτό δεν σημαίνει ότι πρέπει να καθυστερεί η σωστή θεραπεία όταν η κλινική εικόνα είναι σαφής. Αντίστροφα, δεν είναι σωστό να λαμβάνονται παλιά αντιβιοτικά από το σπίτι χωρίς αξιολόγηση, γιατί μπορεί να μην καλύπτουν το μικρόβιο, να είναι ακατάλληλα για τη συγκεκριμένη περίπτωση ή να ευνοούν αντοχές.
Μετά την έναρξη θεραπείας, τα συμπτώματα συνήθως βελτιώνονται μέσα στις πρώτες δύο ημέρες. Αν δεν συμβεί αυτό, χρειάζεται επανεκτίμηση. Δεν είναι καλό να διακόπτεται πρόωρα η θεραπεία «μόλις περάσει το τσούξιμο», αλλά ούτε να επεκτείνεται αυθαίρετα η διάρκεια χωρίς λόγο. Στόχος είναι η σωστή διάρκεια, όχι η μεγαλύτερη δυνατή διάρκεια.
11Πυελονεφρίτιδα και πότε χρειάζεται νοσοκομείο
Η πυελονεφρίτιδα είναι λοίμωξη του ανώτερου ουροποιητικού, δηλαδή του νεφρού. Δεν είναι απλώς μια «δυνατή κυστίτιδα». Συνήθως συνοδεύεται από πυρετό, ρίγος, πόνο στη νεφρική χώρα, ναυτία ή έμετο, ενώ η γενική κατάσταση του ασθενούς είναι πιο επιβαρυμένη. Σε αυτή την περίπτωση, η καλλιέργεια ούρων είναι απαραίτητη και συχνά χρειάζονται και αιματολογικές εξετάσεις, έλεγχος νεφρικής λειτουργίας και σε ορισμένες περιπτώσεις απεικόνιση.
Η νοσηλεία δεν είναι απαραίτητη για όλους, αλλά γίνεται πιο πιθανή όταν ο ασθενής δεν μπορεί να πιει υγρά ή να πάρει αγωγή από το στόμα, όταν υπάρχει χαμηλή πίεση, έντονη καταβολή, εγκυμοσύνη, μεγάλη ηλικία, νεφρική επιβάρυνση, υποψία απόφραξης από λίθο ή σημεία σήψης. Σε τέτοιες περιπτώσεις μπορεί να ξεκινήσει ενδοφλέβια θεραπεία και να γίνει απεικονιστικός έλεγχος για να αποκλειστεί αποφρακτικό αίτιο.
Ένα πολύ σημαντικό πρακτικό σημείο είναι ότι φάρμακα που χρησιμοποιούνται για απλή κυστίτιδα, όπως η νιτροφουραντοΐνη, δεν είναι κατάλληλα για πυελονεφρίτιδα. Ο λόγος είναι ότι δεν επιτυγχάνουν επαρκή επίπεδα στους νεφρούς. Επομένως, ο ασθενής με πυρετό και πόνο στη μέση δεν πρέπει να αυτοθεραπεύεται σαν να έχει απλή κυστίτιδα.
12Ουρολοίμωξη στους άνδρες
Η ουρολοίμωξη στους άνδρες θεωρείται διαφορετική κλινική κατάσταση από την απλή γυναικεία κυστίτιδα. Είναι λιγότερο συχνή και γι’ αυτό, όταν εμφανίζεται, συνήθως χρειάζεται πιο προσεκτική διερεύνηση. Συχνά σχετίζεται με υποκείμενο ουρολογικό παράγοντα, όπως δυσκολία στην κένωση λόγω προστάτη, στένωση, λίθο ή άλλη ανατομική/λειτουργική διαταραχή.
Σε έναν άνδρα με δυσουρία, συχνουρία ή πυρετό, πρέπει να αξιολογηθεί εάν πρόκειται μόνο για ουρολοίμωξη ή αν συνυπάρχει οξεία προστατίτιδα. Η προστατίτιδα μπορεί να δίνει παρόμοια συμπτώματα, αλλά συχνά συνοδεύεται από πυρετό, πόνο στο περίνεο, αίσθημα βάρους και έντονη κακουχία. Σε αυτές τις περιπτώσεις, η διάρκεια και η επιλογή της θεραπείας δεν είναι ίδιες με μιας απλής κυστίτιδας.
Για τον λόγο αυτό, στους άνδρες είναι πιο συχνά απαραίτητη η καλλιέργεια ούρων, η ανασκόπηση του ουρολογικού ιστορικού και ενίοτε ο περαιτέρω έλεγχος με υπέρηχο ή ουρολογική εκτίμηση. Αν συνυπάρχει υπολειπόμενο ούρων, επαναλαμβανόμενες ουρολοιμώξεις ή αιματουρία, η απλή επανάληψη αντιβιοτικών χωρίς έλεγχο είναι συνήθως λανθασμένη προσέγγιση.
13Ουρολοίμωξη στην εγκυμοσύνη
Η ουρολοίμωξη στην εγκυμοσύνη χρειάζεται ιδιαίτερη προσοχή, γιατί συνδέεται με μεγαλύτερο κίνδυνο επιπλοκών τόσο για τη μητέρα όσο και για το έμβρυο. Ακόμη και η ασυμπτωματική βακτηριουρία έχει κλινική σημασία στην κύηση και γι’ αυτό η έγκυος δεν αντιμετωπίζεται όπως ο μη έγκυος πληθυσμός. Η καλλιέργεια ούρων παίζει κεντρικό ρόλο, τόσο για τη διάγνωση όσο και για την παρακολούθηση.
Όταν μια έγκυος έχει συμπτώματα κυστίτιδας ή υποψία πυελονεφρίτιδας, η αξιολόγηση πρέπει να γίνεται έγκαιρα. Επιλέγονται μόνο αντιβιοτικά συμβατά με την κύηση και αποφεύγονται σχήματα που μπορεί να είναι ακατάλληλα για συγκεκριμένο τρίμηνο. Αν υπάρχει πυρετός, πόνος στη μέση ή συστηματική επιβάρυνση, η κατάσταση μπορεί να απαιτεί άμεση ιατρική εκτίμηση και, σε ορισμένες περιπτώσεις, νοσοκομείο.
Σημαντικό είναι επίσης ότι δεν αρκεί να «περάσουν τα συμπτώματα». Στην εγκυμοσύνη συχνά ζητείται επανέλεγχος με καλλιέργεια μετά τη θεραπεία, ώστε να επιβεβαιωθεί ότι το μικρόβιο εκριζώθηκε. Σε έγκυο με υποτροπές μπορεί να χρειαστεί ειδική στρατηγική παρακολούθησης από τον μαιευτήρα και τον θεράποντα ιατρό.
14Ουρολοίμωξη σε παιδιά και εφήβους
Στα παιδιά, η ουρολοίμωξη μπορεί να εκδηλωθεί διαφορετικά από ό,τι στους ενήλικες. Στα μεγαλύτερα παιδιά μπορεί να υπάρχουν κλασικά συμπτώματα όπως τσούξιμο, συχνουρία, δύσοσμα ούρα ή νέο νυχτερινό «βρέξιμο». Στα βρέφη όμως η εικόνα είναι συχνά λιγότερο ειδική: πυρετός χωρίς σαφή εστία, ευερεθιστότητα, κακή σίτιση ή καταβολή. Γι’ αυτό η υποψία πρέπει να είναι υψηλή όταν ένα παιδί έχει πυρετό χωρίς προφανή άλλη εξήγηση.
Η σωστή συλλογή δείγματος στα παιδιά είναι πολύ σημαντική, γιατί τα δείγματα που λαμβάνονται πρόχειρα μολύνονται εύκολα. Σε επιλεγμένες περιπτώσεις, ιδιαίτερα όταν πρόκειται για μικρό παιδί ή εμπύρετη λοίμωξη, μπορεί να χρειαστεί παιδιατρική εκτίμηση και απεικονιστικός έλεγχος, ιδίως αν υπάρχουν υποτροπές ή άτυπα χαρακτηριστικά.
Η πρώτη εμπύρετη ουρολοίμωξη δεν σημαίνει αυτομάτως σοβαρό πρόβλημα, αλλά ούτε και πρέπει να υποτιμάται. Σημασία έχει η έγκαιρη διάγνωση και η σωστή θεραπεία ώστε να μειωθεί ο κίνδυνος επιπλοκών. Στα παιδιά με υποτροπές πρέπει να αναζητηθούν παράγοντες όπως δυσκοιλιότητα, προβλήματα ούρησης, λειτουργικές διαταραχές της κύστης ή ανατομικές ανωμαλίες.
15Υποτροπιάζουσες ουρολοιμώξεις
Ως υποτροπιάζουσες ουρολοιμώξεις περιγράφονται συνήθως τα επεισόδια που εμφανίζονται δύο ή περισσότερες φορές μέσα σε 6 μήνες ή τρεις ή περισσότερες φορές μέσα σε 12 μήνες. Αυτό είναι πολύ συχνό στις γυναίκες και επηρεάζει σημαντικά την ποιότητα ζωής, τον ύπνο, τη σεξουαλική ζωή, την εργασία και την ψυχολογία.
Εδώ είναι απαραίτητο να ξεχωρίσουμε αν πρόκειται για επανεμφάνιση του ίδιου μικροβίου, για νέα λοίμωξη με διαφορετικό μικρόβιο ή για επεισόδια που μοιάζουν με ουρολοίμωξη αλλά στην πραγματικότητα είναι κάτι άλλο, όπως σύνδρομο επώδυνης κύστης, ατροφική κολπίτιδα, ουρηθρικό ερεθισμό ή γυναικολογική φλεγμονή. Γι’ αυτό, στις υποτροπές η καλλιέργεια ούρων αποκτά ακόμη μεγαλύτερη αξία.
Η διερεύνηση δεν σημαίνει απαραίτητα επιθετικό έλεγχο για όλους. Σε νέα γυναίκα χωρίς παράγοντες κινδύνου, χωρίς αιματουρία και χωρίς άτυπα στοιχεία, συχνά δεν χρειάζεται άμεσα εκτενής απεικονιστικός έλεγχος. Όμως αν υπάρχουν υποψίες για λίθο, απόφραξη, νευρογενή κύστη, καθετήρα, ιστορικό χειρουργείου ή επιμένουσα αιματουρία, τότε αλλάζει η προσέγγιση.
Σε επίπεδο πρόληψης, μπορεί να εξεταστούν στρατηγικές όπως αύξηση υγρών, τοπικά κολπικά οιστρογόνα σε μετεμμηνοπαυσιακές γυναίκες, μεθεναμίνη σε επιλεγμένες περιπτώσεις, post-coital προφύλαξη όταν υπάρχει σαφής σχέση με τη σεξουαλική επαφή, ακόμη και αυτοεκκίνηση θεραπείας σε πολύ επιλεγμένες και καλά εκπαιδευμένες ασθενείς. Συμπληρώματα όπως το cranberry ή η D-μαννόζη συζητούνται συχνά, αλλά η αποτελεσματικότητά τους δεν είναι ίδια σε όλες τις μελέτες και δεν πρέπει να παρουσιάζονται σαν βέβαιη λύση.
| Στρατηγική | Πού βοηθά περισσότερο | Τι να θυμάστε |
|---|---|---|
| Αύξηση υγρών | Σε γυναίκες με χαμηλή ημερήσια πρόσληψη υγρών | Απλό μέτρο, όχι επαρκές μόνο του σε όλες τις περιπτώσεις |
| Κολπικά οιστρογόνα | Μετεμμηνοπαυσιακές γυναίκες | Χρήσιμα όταν υπάρχει ατροφία/ξηρότητα και συχνές υποτροπές |
| Μεθεναμίνη | Επιλεγμένες γυναίκες χωρίς ουρολογικές ανωμαλίες | Συζητείται ως εναλλακτική της συνεχούς αντιβίωσης |
| Post-coital προφύλαξη | Όταν τα επεισόδια σχετίζονται καθαρά με επαφή | Θέλει ιατρική καθοδήγηση, όχι αυθαίρετη χρήση |
| Συνεχής χαμηλή προφύλαξη | Σε συχνές, τεκμηριωμένες υποτροπές | Επιλογή δεύτερης γραμμής λόγω κινδύνου αντοχής |
16Πώς μπορείτε να προλάβετε τα επεισόδια
Η πρόληψη δεν βασίζεται σε έναν «μαγικό κανόνα». Συνήθως περιλαμβάνει συνδυασμό απλών μέτρων. Η επαρκής ενυδάτωση, η αποφυγή παρατεταμένης κατακράτησης ούρων, η σωστή αντιμετώπιση της δυσκοιλιότητας και η καλή κένωση της κύστης είναι πρακτικά μέτρα που έχουν σημασία. Σε άτομα με συσχέτιση με τη σεξουαλική επαφή, η ούρηση μετά την επαφή μπορεί να βοηθά ως μέρος μιας συνολικής στρατηγικής.
Δεν χρειάζονται ακραίες ή επιθετικές πρακτικές υγιεινής. Τα πολύ συχνά αντισηπτικά, τα ερεθιστικά καθαριστικά και η υπερβολική τοπική «αποστείρωση» μπορεί να διαταράξουν το φυσιολογικό περιβάλλον και να επιδεινώσουν το πρόβλημα. Επίσης, η εμμονή με συνεχείς τυχαίες γενικές ούρων «για να δω αν είμαι καλά» συνήθως δεν βοηθά και συχνά οδηγεί σε υπερδιάγνωση και άσκοπες αγωγές.
Σε μετεμμηνοπαυσιακές γυναίκες με συχνές υποτροπές, η συζήτηση για κολπικά οιστρογόνα έχει πρακτική αξία. Σε επιλεγμένες ασθενείς, μπορεί επίσης να συζητηθούν εναλλακτικές στρατηγικές αντί για συνεχείς αντιβιώσεις. Το σωστό πλάνο πρόληψης είναι αυτό που ταιριάζει στο προφίλ του ασθενούς και όχι μια τυποποιημένη συνταγή που εφαρμόζεται σε όλους.
17Ουρολοίμωξη και σεξουαλική ζωή
Η ουρολοίμωξη δεν είναι από μόνη της σεξουαλικώς μεταδιδόμενο νόσημα. Ωστόσο, η σεξουαλική επαφή μπορεί να αυξήσει την πιθανότητα ουρολοίμωξης, κυρίως επειδή διευκολύνει τη μεταφορά βακτηρίων προς την ουρήθρα. Αυτό εξηγεί γιατί κάποιες γυναίκες έχουν επεισόδια σχεδόν αποκλειστικά μετά από επαφή.
Αυτό δεν σημαίνει ότι κάθε ενοχλητικό σύμπτωμα μετά από επαφή είναι ουρολοίμωξη. Αν υπάρχει κολπικό έκκριμα, ερεθισμός, κνησμός, πόνος στη σεξουαλική επαφή ή συμπτώματα από τον σύντροφο, τότε πρέπει να αποκλειστεί και άλλη αιτία, όπως κολπίτιδα ή σεξουαλικώς μεταδιδόμενη λοίμωξη. Η απλή λήψη αντιβιοτικού «για κάθε ενδεχόμενο» μπορεί να καλύψει προσωρινά συμπτώματα και να καθυστερήσει τη σωστή διάγνωση.
Σε ασθενείς με σαφή post-coital υποτροπή, ο γιατρός μπορεί να συζητήσει συγκεκριμένες στρατηγικές πρόληψης. Επίσης, αν το πρόβλημα επηρεάζει τη σεξουαλική ζωή ή δημιουργεί άγχος, αυτό αξίζει να αναφερθεί. Η ποιότητα ζωής είναι σημαντικό κομμάτι της θεραπευτικής προσέγγισης και όχι «δευτερεύουσα λεπτομέρεια».
18Συχνά λάθη και τι δεν πρέπει να κάνετε
Το πιο συχνό λάθος είναι η αυτοθεραπεία με παλιά αντιβιοτικά. Το ότι ένα φάρμακο βοήθησε πριν από έναν χρόνο δεν σημαίνει ότι θα βοηθήσει και τώρα. Το μικρόβιο μπορεί να είναι διαφορετικό, μπορεί να έχει αλλάξει η αντοχή του ή μπορεί η τωρινή ενόχληση να μην είναι καν ουρολοίμωξη. Η αυθαίρετη χρήση αντιβιοτικών αυξάνει την πιθανότητα ανθεκτικών στελεχών και κάνει τα μελλοντικά επεισόδια πιο δύσκολα στη διαχείριση.
Δεύτερο συχνό λάθος είναι η θεραπεία κάθε θετικής καλλιέργειας χωρίς συμπτώματα. Αυτό συμβαίνει συχνά σε ηλικιωμένους, σε άτομα με καθετήρες ή σε προληπτικούς ελέγχους. Όμως το αποτέλεσμα της καλλιέργειας πρέπει να ερμηνεύεται μαζί με την κλινική εικόνα. Η άσκοπη θεραπεία της ασυμπτωματικής βακτηριουρίας είναι κλασικό παράδειγμα υπερθεραπείας.
Άλλο συχνό λάθος είναι η παράβλεψη της επιμένουσας αιματουρίας. Αν η αιματουρία συνεχίζεται μετά την υποχώρηση της λοίμωξης ή επανέρχεται επανειλημμένα, δεν πρέπει να θεωρείται αυτομάτως «φυσιολογική από την κυστίτιδα». Μπορεί να χρειάζεται περαιτέρω έλεγχος. Τέλος, δεν πρέπει να ξεχνάμε ότι η αποτυχία θεραπείας μπορεί να σημαίνει λάθος διάγνωση, όχι μόνο λάθος αντιβιοτικό.
19Πότε χρειάζεται υπέρηχος ή περαιτέρω έλεγχος
Δεν χρειάζεται κάθε ασθενής με πρώτη απλή κυστίτιδα υπέρηχο. Ο περαιτέρω έλεγχος έχει μεγαλύτερη αξία όταν υπάρχουν υποτροπές, ουρολοίμωξη σε άνδρα, επιμένουσα αιματουρία, ιστορικό λίθων, υποψία απόφραξης, νεφρική δυσλειτουργία, κακή ανταπόκριση στη θεραπεία ή ειδικοί παράγοντες όπως νευρογενής κύστη και υπολειπόμενα ούρα.
Ο υπέρηχος νεφρών και ουροδόχου κύστης είναι συχνά η πρώτη απεικονιστική εξέταση, γιατί είναι μη επεμβατικός και μπορεί να δείξει διάταση, λίθο, υπολειπόμενα ούρα ή άλλη ουρολογική διαταραχή. Σε πιο σύνθετες περιπτώσεις μπορεί να χρειαστεί αξονική ή άλλη εξειδικευμένη εξέταση, ιδιαίτερα όταν υπάρχει υποψία αποφρακτικής πυελονεφρίτιδας ή επιπλοκής.
Σε ασθενείς με πολύ συχνές υποτροπές, ο έλεγχος δεν αφορά μόνο την ανατομία. Μπορεί να χρειάζεται και αξιολόγηση της λειτουργίας της κύστης, της δυσκοιλιότητας, του σακχάρου, των γυναικολογικών παραγόντων ή της εμμηνοπαυσιακής ατροφίας. Η ουρολοίμωξη δεν είναι πάντα μόνο «μικρόβιο». Συχνά είναι το αποτέλεσμα μιας προδιάθεσης που μπορεί να διορθωθεί ή να ελεγχθεί.
20Συχνές ερωτήσεις
Χρειάζεται πάντα καλλιέργεια ούρων;
Όχι σε όλες τις περιπτώσεις. Σε μια τυπική απλή κυστίτιδα σε υγιή μη έγκυο γυναίκα μπορεί η διάγνωση να τεθεί κυρίως κλινικά, αλλά καλλιέργεια είναι ιδιαίτερα χρήσιμη σε πυρετό, εγκυμοσύνη, άνδρες, παιδιά, υποτροπές, άτυπα συμπτώματα ή αποτυχία της αρχικής θεραπείας.
Μπορεί να έχω θετική καλλιέργεια χωρίς να χρειάζομαι αντιβίωση;
Ναι. Αυτό λέγεται ασυμπτωματική βακτηριουρία και συνήθως δεν θεραπεύεται, εκτός από ειδικές περιπτώσεις όπως η εγκυμοσύνη ή πριν από ορισμένες ουρολογικές επεμβάσεις.
Πότε πρέπει να ανησυχήσω ότι η ουρολοίμωξη έχει «ανέβει» στους νεφρούς;
Όταν υπάρχουν πυρετός, ρίγος, πόνος στη μέση ή στο πλάι, ναυτία, έμετοι και πιο βαριά γενική εικόνα. Αυτά είναι συμβατά με πυελονεφρίτιδα και χρειάζονται άμεση ιατρική εκτίμηση.
Είναι μεταδοτική η ουρολοίμωξη;
Η ουρολοίμωξη δεν θεωρείται σεξουαλικώς μεταδιδόμενο νόσημα, αλλά η σεξουαλική επαφή μπορεί να αυξήσει τον κίνδυνο επεισοδίου σε ορισμένα άτομα, κυρίως λόγω μεταφοράς βακτηρίων προς την ουρήθρα.
Τι σημαίνει αν η γενική ούρων δείξει αίμα;
Η αιματουρία μπορεί να εμφανιστεί σε κυστίτιδα, αλλά δεν είναι ειδική. Αν επιμένει μετά τη θεραπεία ή επανέρχεται συχνά, χρειάζεται περαιτέρω αξιολόγηση και δεν πρέπει να αποδίδεται αυτόματα πάντα σε ουρολοίμωξη.
Μπορεί η ουρολοίμωξη να σχετίζεται με τον διαβήτη;
Ναι. Ο σακχαρώδης διαβήτης αυξάνει τον κίνδυνο ουρολοιμώξεων και υποτροπών, ιδιαίτερα όταν η ρύθμιση του σακχάρου δεν είναι καλή ή όταν συνυπάρχει υπολειπόμενο ούρων ή άλλος ουρολογικός παράγοντας.
Αν είμαι έγκυος, αλλάζει η αντιμετώπιση;
Ναι. Στην εγκυμοσύνη η καλλιέργεια ούρων έχει ιδιαίτερη σημασία και η επιλογή αντιβιοτικού πρέπει να είναι συμβατή με την κύηση. Ακόμη και η ασυμπτωματική βακτηριουρία μπορεί να χρειάζεται θεραπεία.
Ποια είναι η διαφορά ανάμεσα σε υποτροπή και νέα λοίμωξη;
Υποτροπή μπορεί να σημαίνει παραμονή ή επανεμφάνιση του ίδιου προβλήματος, ενώ νέα λοίμωξη μπορεί να οφείλεται σε διαφορετικό μικρόβιο. Η καλλιέργεια και το αντιβιόγραμμα βοηθούν να ξεκαθαρίσει αυτή η διαφορά.
21Τι να θυμάστε
• Η ουρολοίμωξη δεν είναι πάντα ίδια νόσος. Άλλο η απλή κυστίτιδα, άλλο η πυελονεφρίτιδα, άλλο η ασυμπτωματική βακτηριουρία.
• Τα συμπτώματα καθοδηγούν την ερμηνεία των εξετάσεων. Μια θετική καλλιέργεια χωρίς συμπτώματα δεν σημαίνει πάντα θεραπεία.
• Η σωστή συλλογή δείγματος είναι θεμελιώδης. Κακή λήψη μπορεί να οδηγήσει σε λάθος διάγνωση και άσκοπη αντιβίωση.
• Πυρετός, πόνος στη μέση, εγκυμοσύνη, άνδρας ή υποτροπές αλλάζουν το επίπεδο εγρήγορσης.
• Η πρόληψη και η σωστή διερεύνηση μειώνουν τις υποτροπές περισσότερο από την τυχαία επανάληψη αντιβιοτικών.
22Κλείστε Ραντεβού & Βιβλιογραφία
Ερμηνεία αποτελεσμάτων από ιατρό στο εργαστήριό μας. Μπορείτε να προγραμματίσετε εξέταση ή να δείτε τον πλήρη κατάλογο διαθέσιμων εξετάσεων.
https://uroweb.org/guidelines/urological-infections
https://www.nice.org.uk/guidance/ng109
https://www.nice.org.uk/guidance/ng111
https://www.nice.org.uk/guidance/ng112
https://www.idsociety.org/practice-guideline/asymptomatic-bacteriuria/
https://www.acog.org/clinical/clinical-guidance/clinical-consensus/articles/2023/08/urinary-tract-infections-in-pregnant-individuals
https://mikrobiologikolamia.gr/katalogos-eksetaseon/
Δρ. Παντελής Αναγνωστόπουλος, Ιατρός Μικροβιολόγος – Βιοπαθολόγος
Μικροβιολογικό Εργαστήριο Λαμίας, Έσλιν 19, Λαμία 35100
📞 +30-22310-66841 • Δευτέρα–Παρασκευή 07:00–13:30